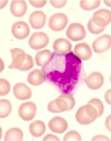
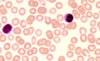

Bindevæv inddeles i
Egentlige- & Specialiseret bindevæv
Egentlige bindevæv inddeles i
Egentlige bindevæv:
1. Løst bindevæv
2. Tæt firbrøst bindevæv
=>Tæt regelmæssigt bindevæv
=> Tæt uregelmæssigt bindevæv
=> Tæt elastisk bindevæv
3. Mukøst bindevæv
3. Retikulært bindevæv
Specialiseret bindevæv inddeles i
Specialiseret bindevæv:
1. Fedtvæv
2. Brusk
3. Knoglevæv
4. Knoglemarv
5. Blod
Egentlige bindevævs funktion
- Støttevæv fordi; udgør et “skelet”
- Udfylder hulrum mellem andre væv: tilhæfter, støtter og afgrænser
- Fungere som ernæringsvej for avaskulære væv fx epithelvæv
- Sæde for inflammation (foregår i løst bindevæv)
Karakteristik af egentlige bindevæv
Indeholder celler og ekstracellulære matrix
Ekstracellulære matrix
Består af fibre indlejret i en grundsubstans.
Kategorier af fibre
- Kollagene fibre
- Retikulære fibre
- Elastiske fibre
Funktion af fibre
- Mekanisk støtte og styrke: kollagene og retikulære fibre
- Elasticitet: elastiske fibre (kan strækkes op til 150% af oprindelig længde)
Grundsubstans
Består af proteoglykaner og adhæsive glykoproteiner
Proteoglykaner: kæder af glukoseaminoglykaner (GAG)

Funktion af grundsubstans
- Glykosaminoglykaner og proteoglykaner
=> danner en gel, der fungere som:
Diffusionsmedie
Yder modstand mod kopression - Adhæsive glykoproteiner fungere som:
Celleforankring til ECM
Styrer cellevandring
Kollagene fibre
Er den hyppigst forekommende fibre i bindevæv
Funktion:
giver trækstyrke
Opbygning:
fibrene er opbygget af firbriller
fiber tykkelse: 1-20 𝜇m
fibril tykkelse: 30-300 nm
Farvninger:
HE: lyserøde med eosin
Mallory: blå
Van Gieson, siriusrødt og Verhoeff: farves røde

Kollagenmolekyle inddeles i:
28 forskellige typer af kollagen
Huskeregel (ABCD):
Type I: næsten Alle steder (dermis, sener, blodkar & knogler)
Type II: i Brusk
Type III: i retiCulære fibre
Type IV: kun i lamina Densa (del af BL)
Chondrocytterne undergår mitotisk deling, hvorved der dannes isogene gru
Retikulære fibre
Struktur:
danner fine net
Består af:
type III kollagen
Farvninger:
HE: ses IKKE i denne farvning.
Sølvfarvning: sort/brunt
PAS-farvning: farves røde.

Elastiske fibre
Struktur:
tynde tråde i løst bindevæv (diameter: 0,2-1 µm)
Funktion:
kan strækkes op til 150% af oprindelig længde
Farvninger:
Frisk: gullige
HE: svagt lyserøde af eosin
Orcein: rødbrune
Verhoeff: sorte

Celletyper i bindevæv
Fikserende- & Vandrende celler
Fikserende celler
Fikserende celler:
1. Fibroblaster
2. Reticulumceller
3. Mesenchymale celler
4. Adipocytter (fedtceller)
Vandrende celler
Vandrer ud i bindevævet fra blodbanen
Vandrende celler:
1. Monocytter
2. Makrofager
3. Dendritiske celler
4. Lymforcytter
5. Plasmaceller
6. Granulocytter
7. Mastceller
Fikserende celler - Fibroblaster
- De egentlige bindevævsceller
- Hyppigst celler i bindevæv
- Danner komponenter til ekstracellulær matrix
Lysmikroskopet
celler: tenformede
cellekerne: affladet kerne med 1-2 nucleoli

Fikserende celler - Reticulumceller
- Danner retikulære fibre i lymfoide
Lysmikroskopet
celle: stjerneformede
cellekerne: ovale kerner

Fikserede celler - Mesenchymale celler
- Stamceller
=> kan differentiere til bl.a. fibroblaster
Lysmikroskopet
celle: stjerneformede

Fedtcellers funtkion
oplagring af triglycerider
Fikserende celler - Adipocytter (fedtceller)
- Fedtlagring
Lysmikroskopet
celler: runde celler (fedtcellen omgivs af retikulære fibre)
cellekerne:affladet kerne, befinder sig perifert

Vandrende celler - Monocytter
- Dannes i knoglemarv og går til blod og dernæst bindevæv
- Differentiere til makrofager i bindevæv
Lysmikroskop
celle: svagt farvet cytoplasma
cellekerne: bønneformet kerne (excentrisk, uden for centrum)
Vandrende celler - Makrofager
- Monocytter differentiere til makrofager i BV
- Fagocytose og antigen-præsenterende
Lysmikroskop fikse makrofager (hyppigste)
celle: tenformede (diameter: 15 µm)
cellekerne: lille mørk kerne
Lysmikroskop frie makrofager
celle: arundede celler (diameter: 15-20 µm)